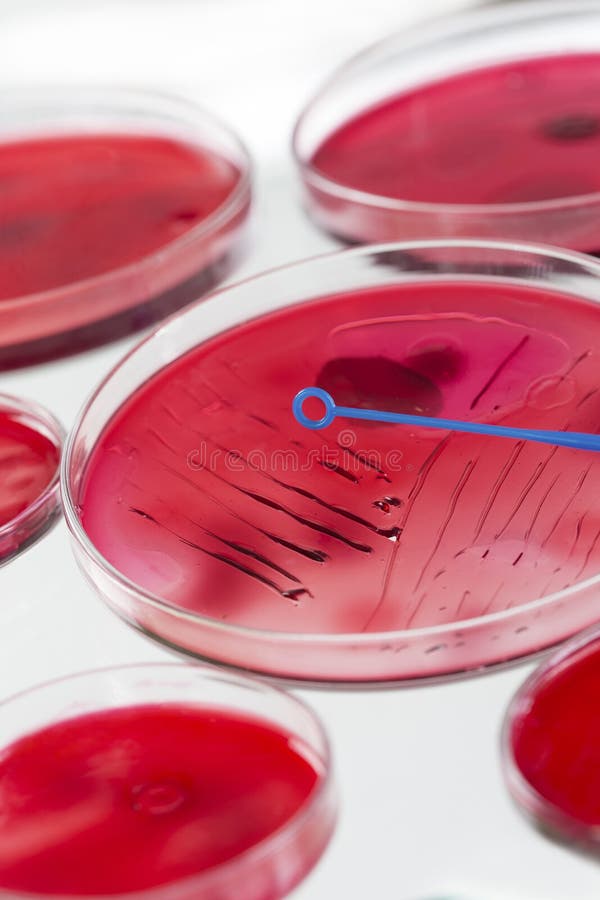

Типы вакцин и их применение в микробиологии

Раздел: Лаборатория идей